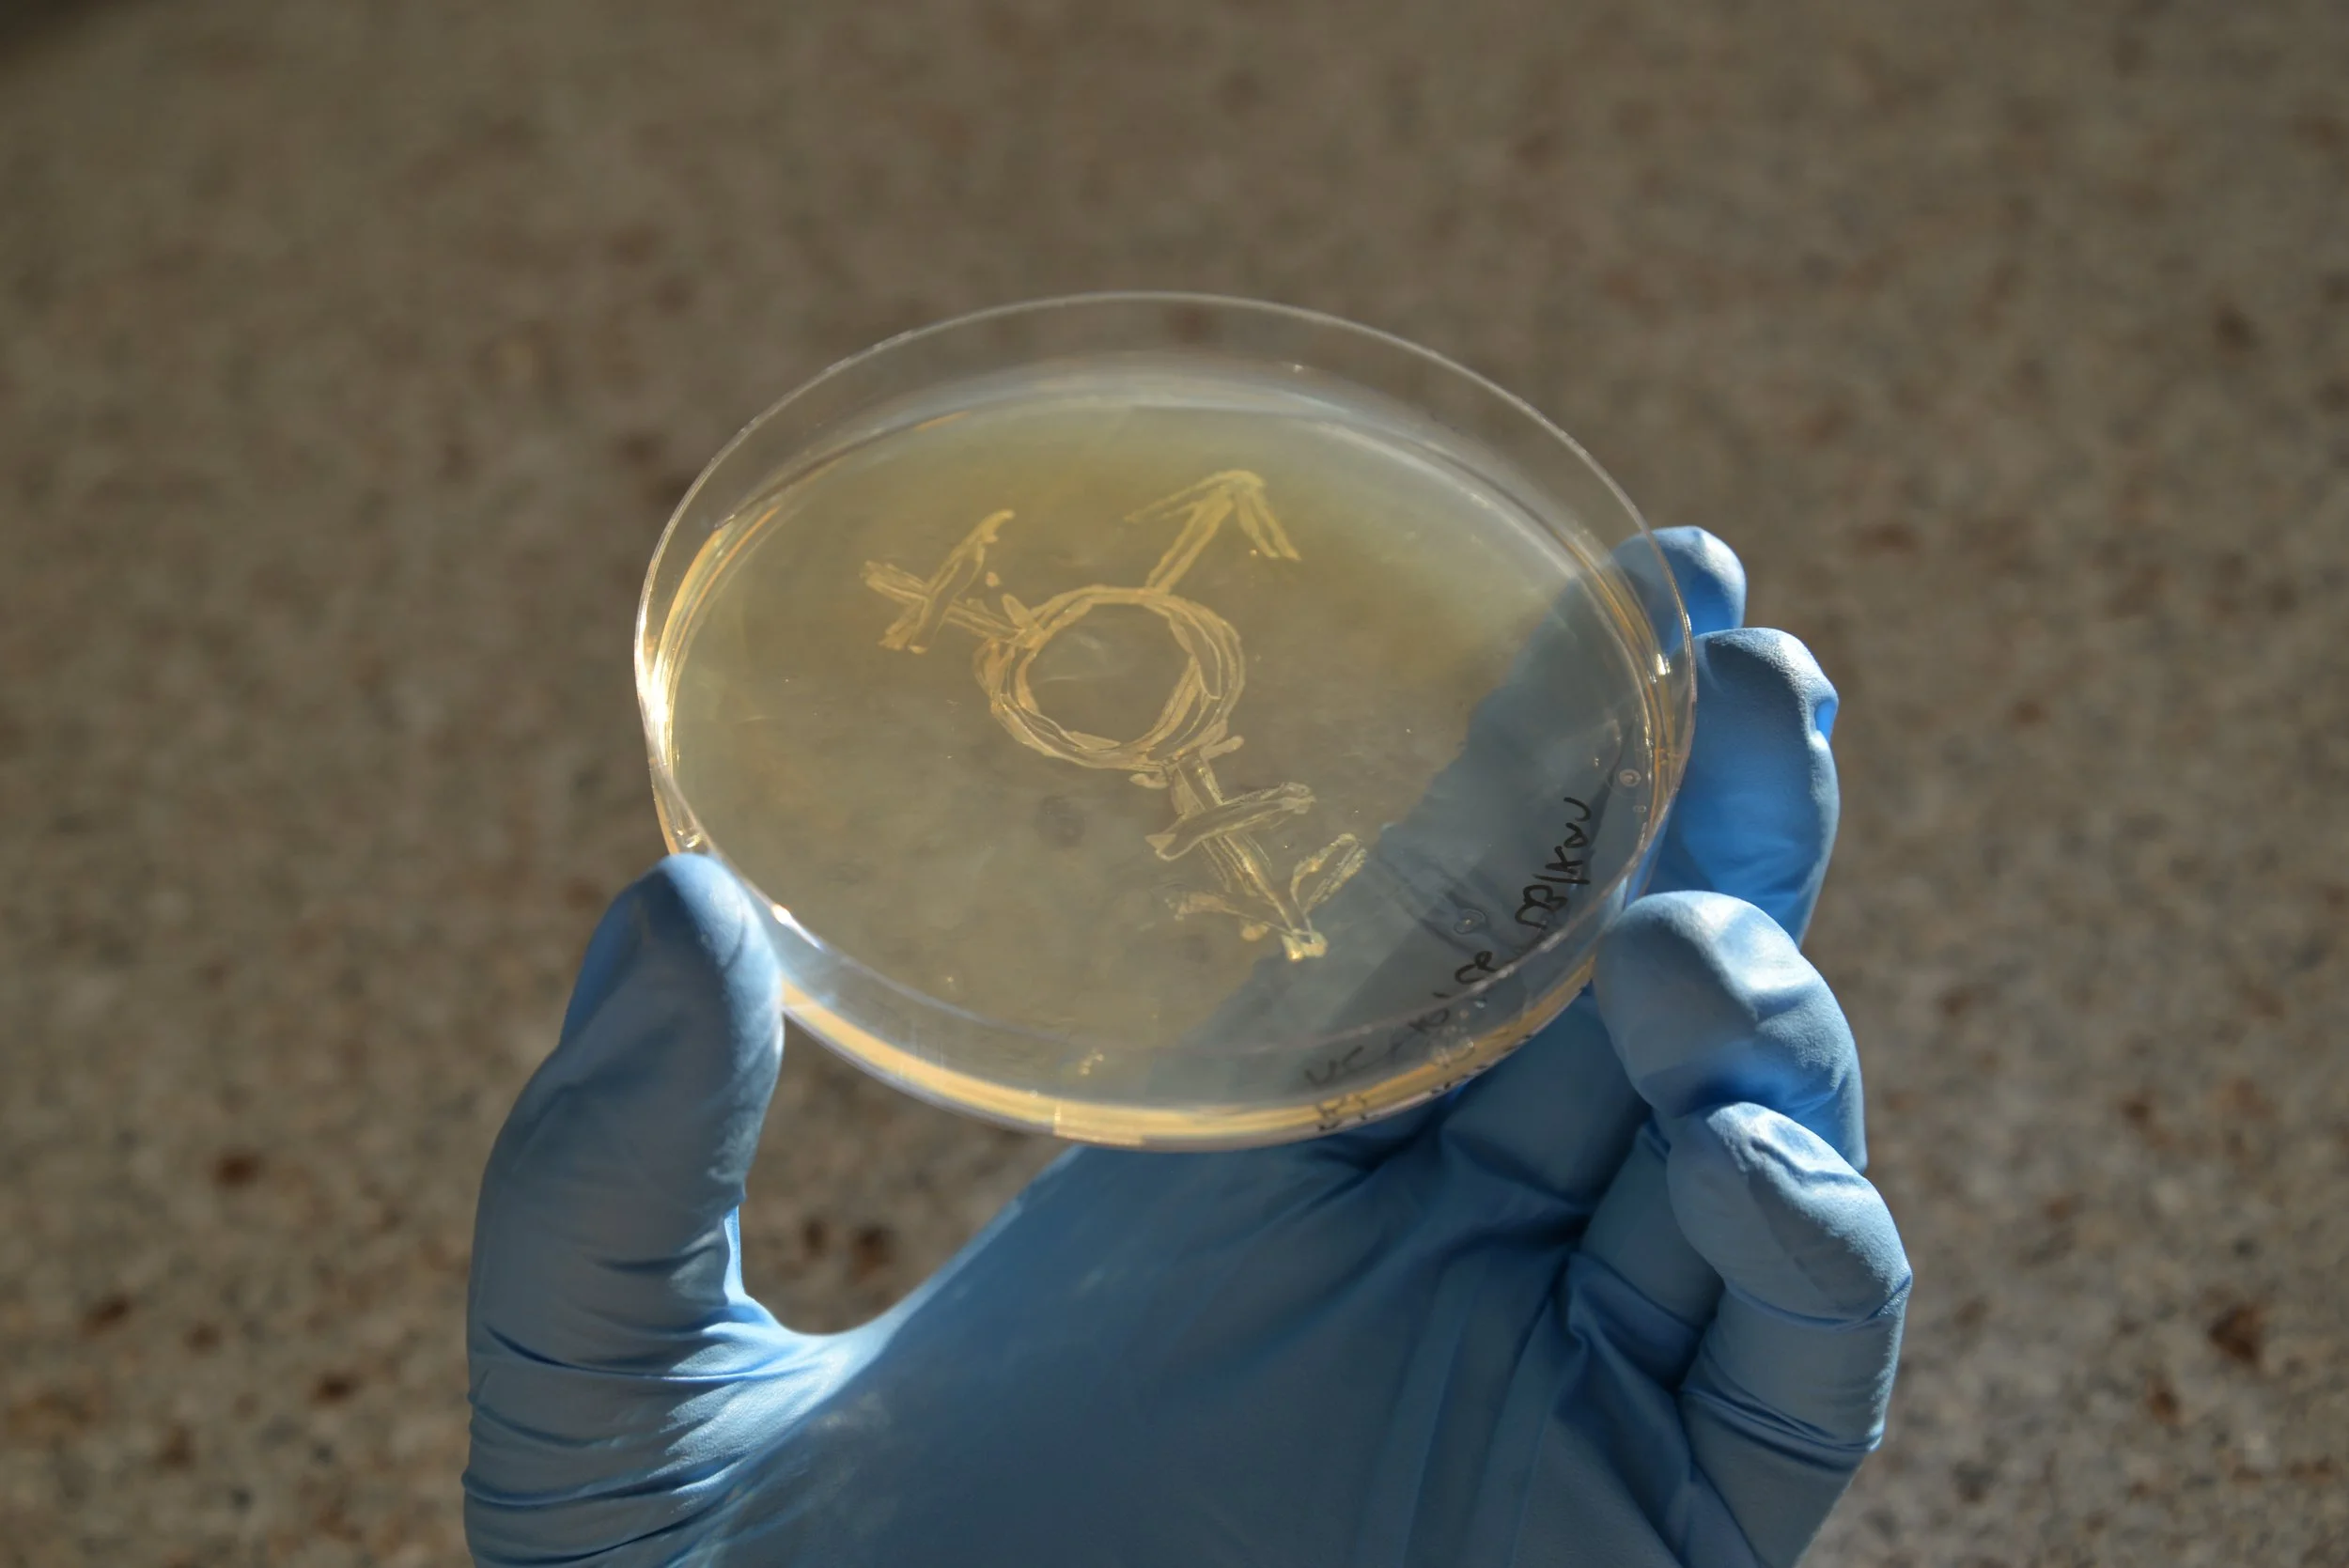

Systems
International society of Nonbinary Scientists
I was a founding member of ISNBS and am dedicated to helping it grow and develop as an organization. We are creating a world where people outside the gender binary have the support and community they need to pursue their interests.
Past
Virginia Scientist-Community Interface
I spent several years as a member of the executive board of the Virginia Scientist-Community Interface, and also previously led its communications team. We put science and engineering in the hands of advocates and activists who don’t have access to knowledge they need.
How to Take Down a Pipeline (And Win) - The Equation
The Future Economy Collective
I was a volunteer with the Future Economy Collective, a mutual aid organization in the New River Valley. I planned a lot of events and designed a lot of t-shirts. The group has a community fridge and runs mutual aid events. They provide meeting space for other groups and projects to do their work.